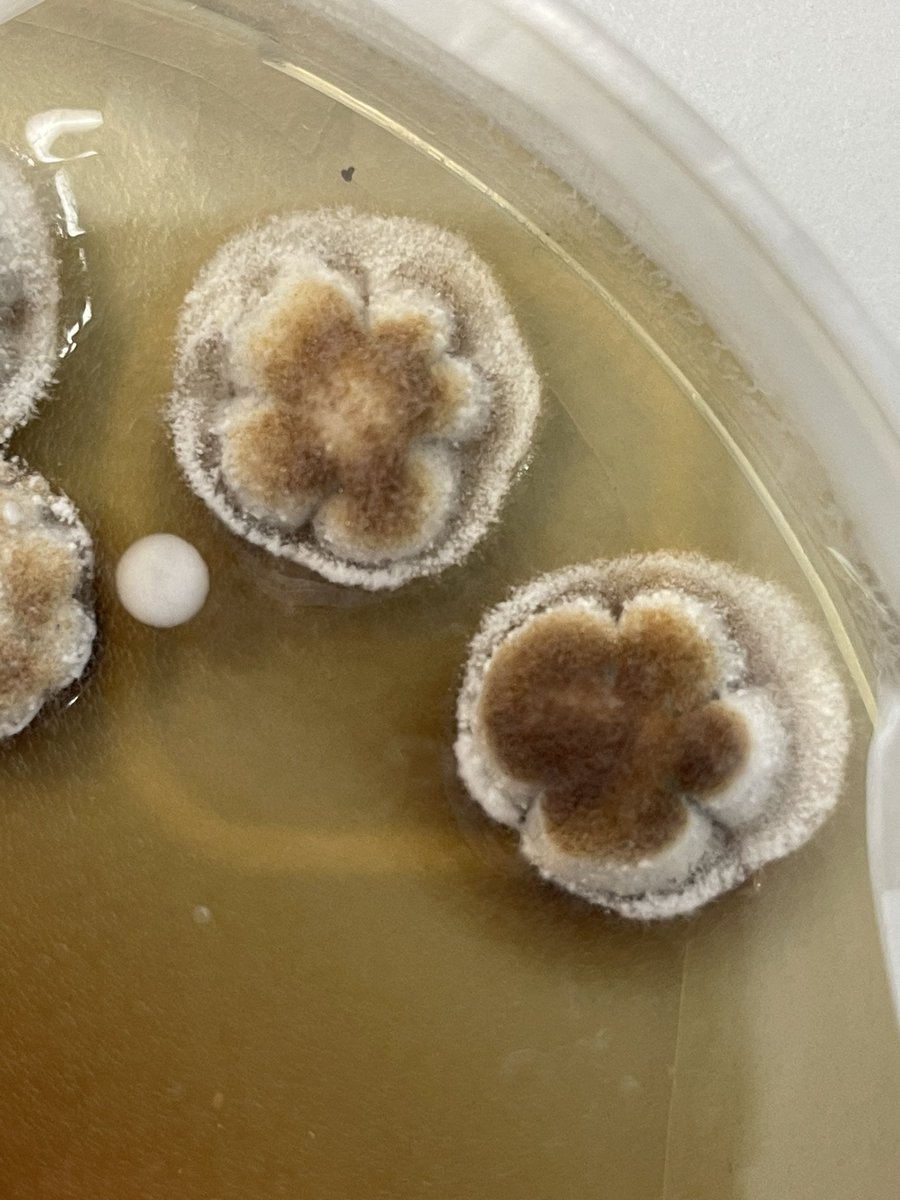
Chris Pull tweet media

Sabitlenmiş Tweet
Chris Pull
1.7K posts


Chris Pull retweetledi
#ProcB Transcriptomic responses to location learning by #honeybee dancers are partly mirrored in the #brains of dance-followers ow.ly/ZvjU50Qkzmt #OpenAccess @ElliLeadbeater1 @yannick__ @WaspWoman @fmanfredini79

English
Chris Pull retweetledi

The brains of bees who follow a dance have a similar molecular signature to the dancers they followed! 🐝🧠🧬 Extremely excited to see our research published in #ProcB today: here 👉🏽 royalsocietypublishing.org/doi/10.1098/rs… with @ElliLeadbeater1, @yannick__ , @WaspWoman, @RSocPublishing

English

Amazing conference @BristolBioSci! And I'm very proud of @OxfordBiology MBiol student @bizzell_flynn who won best student talk for his masters work!
English
Chris Pull retweetledi
Chris Pull retweetledi

🎺🎺Post doc available 🎺
Modelling movement of released Gamebirds to understand their management & ecological effects (iSSF, ABM, spatial skills, conservation)
Starting September. Advert out soon. DM me now to discuss
I'm at #behaviour2023 so can chat F2F if you're there too

English

Update on the weird fungus. It was plated up and took a few weeks, but today I noticed it's finally produced new "spores". Next step, can we infect the ants and replicate the same biting phenotype?
Chris Pull@chris_pull
Weird observation...these ants look like they're doing the biting death grip seen in "zombie" ants and they have an unusual, globular like fungus growth on them. @CharissaB/@another_ant_guy?
English

@PepijnKooij We will do if it turns out to be something interesting!
English

@chris_pull Did you try to sequence the ITS region for identification?
English
Chris Pull retweetledi

Really pleased to see our review on best practices for insect olfactometer experiments published today!
This has been three years in the making and wouldn't have been completed without major contributions from @ipm_tom , @EdHarris9000 and @benclunie.
onlinelibrary.wiley.com/doi/10.1111/ee…
English
Chris Pull retweetledi

Our new paper is out today in @RSocPublishing Interface journal (@MarieRAttard @bowen_james @GroupBowen). All about eggshell surface texture. Paper link ⬇️. Thank you @LeverhulmeTrust for funding, & @NHM_Oology @NHM_Tring for samples! #birds #ornithology @RHULBioSci @RHULScience




English
Chris Pull retweetledi

Planning on applying for a 2024 ERC Starting Grant? The call is now open!
Application portal 👉 bit.ly/StGApply2024
ERC 2024 Work Programme 👉 bit.ly/ERC2024WP
And remember, the deadline to apply for an #ERCStG is 24 October 2023!

English
Chris Pull retweetledi

Interested in #collectivebehaviour, #decisionmaking, and #ants? Check out my first #PhD paper, out today in @PNASNews!
@ChrisRReid1, @sjmgarnier, Chris Lustri, @MarineMcnab, and I studied how colonies of ants make decisions when facing an uncertain task
pnas.org/doi/10.1073/pn…
English

Almost 12 years ago a I started my final year research project with @sphaerularia collecting ant queens...tonight I'm back at it again! Must've collected a good 300-400!

English

@CharissaB @another_ant_guy Some marginally better pictures. Very weird but very interesting!


English

Weird observation...these ants look like they're doing the biting death grip seen in "zombie" ants and they have an unusual, globular like fungus growth on them. @CharissaB/@another_ant_guy?


English

@CharissaB @another_ant_guy Yeah, I noticed it today when feeding the colony. Some of them has been dismantled by other ants by the looks of things. I have put the dish into a moist petri to see what grows! I may send you a PM about next steps if it does...
English






